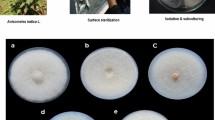

Abstract
I CAN assure the secretary of the Bihar Planters' Association that the comments upon their neglect of scientific method when they were first brought into competition with synthetic indigo which I felt bound to make were prompted solely in the interests of the native industry. It is practically conceded in the foregoing communication that there has been such neglect, and that the practical outcome of the revision of their processes has been the halving of the cost of production of the natural product in the course of a few years. This is satisfactory so far as it goes, but the main issue is still left very doubtful. In spite of the reduction of the cost of production by one-half, it appears that they are still in India at the mercy of climatic conditions, and even then, supposing these to be favourable for a few seasons, they have only “every reason to hope” that they will be able to compete with their coal-tar rival. Those who have at heart the welfare of our Indian Empire will cordially endorse the wish that their hope may be realised, but the point at issue between the report to the Indian Government and the Planters' Association is really whether finality has been reached in the way of improvement. According to the statement of the secretary, they have been advised that no further improvement in the “main processes” is possible. The results of the application of the newer methods of analysis indicate clearly enough that there is more indigotin in the plants than has hitherto been suspected. The advisers to the association certainly do “brush aside” this work done at Leeds if they authorise the secretary to state “they have satisfied themselves that this evidence is erroneous”. Those who in common with myself have looked critically, and, I may say, quite impartially into the evidence have come to the conclusion that the analytical methods are quite dependable. Others will no doubt corroborate this statement. After the publication of the report the Planters' Association held a meeting, at which they passed a resolution expressing confidence in, and practically endorsing the opinion of, their own advisers, in face of the new evidence offered from the Leeds laboratory. I gathered this information from a report of the meeting in one of the Indian papers, which was forwarded to me at the time. This attitude, which may fairly be described as one of hostility, would have been stiffened by the above letter were it not therein admitted that the “biological side” of the problem is still in its infancy, and that further development in this direction is anticipated. Also it is conceded that “an entirely independent opinion” in the matter of the manufacturing processes) is to be obtained. Thus all the contentions of those who felt the ignominy of this great Indian industry “taking its whipping in a crouching attitude” are likely to be met, and our best wishes are, it is needless to say, with the planters. If they are, by the inexorable laws of nature, beaten in the long run, it will at any rate redound to their credit that they did not succumb without a good fight.
This is a preview of subscription content, access via your institution
Access options
Subscribe to this journal
Receive 51 print issues and online access
$199.00 per year
only $3.90 per issue
Buy this article
- Purchase on SpringerLink
- Instant access to the full article PDF.
USD 39.95
Prices may be subject to local taxes which are calculated during checkout
Similar content being viewed by others
Rights and permissions
About this article
Cite this article
MELDOLA, R. Research Work on Natural Indigo. Nature 78, 540–541 (1908). https://doi.org/10.1038/078540b0
Issue date:
DOI: https://doi.org/10.1038/078540b0